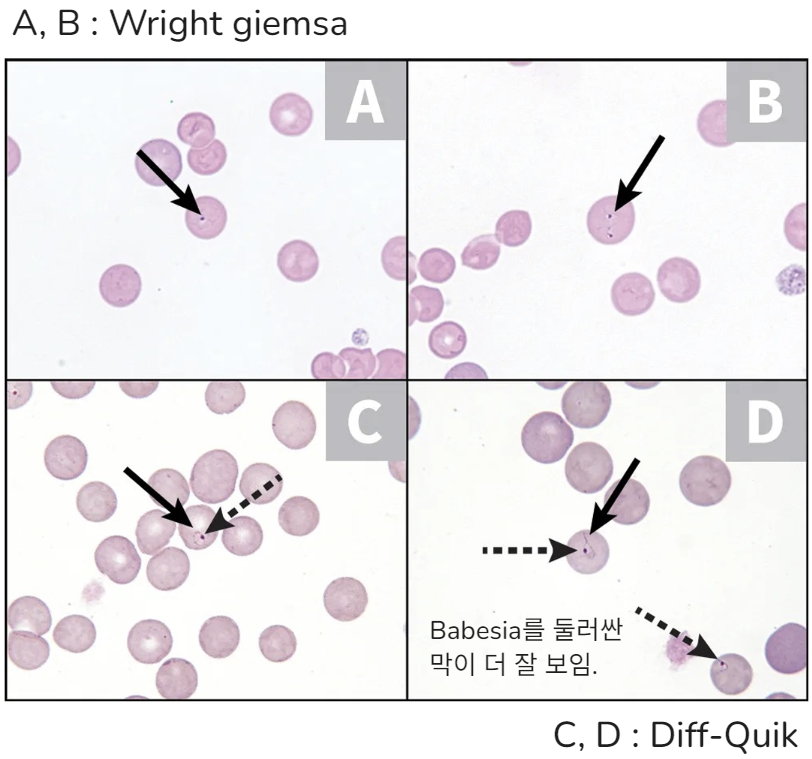
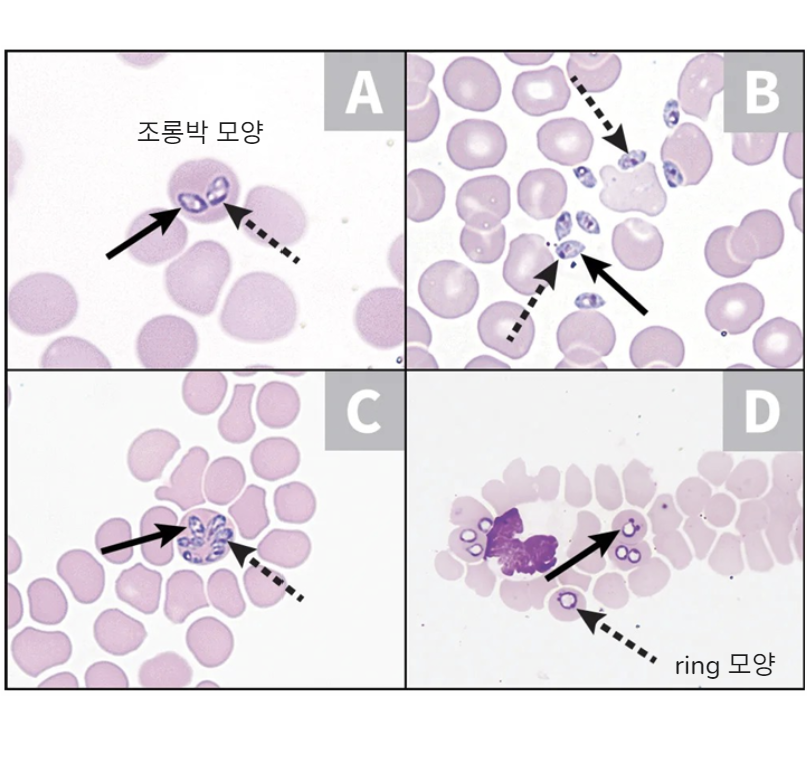
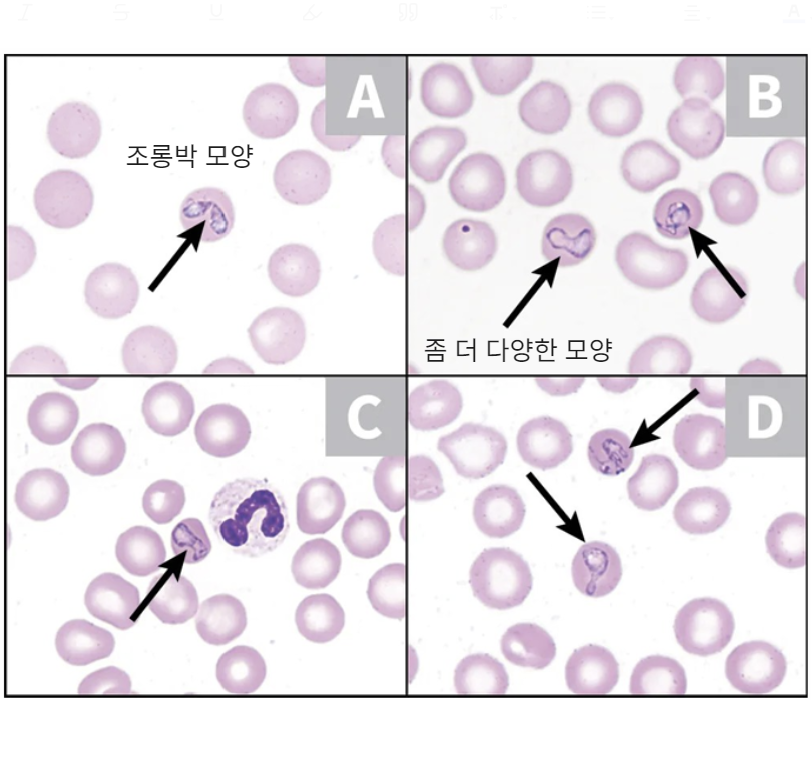

๋ชฉ์ฐจ
- 1. Etiology & Epidemiology
- 2. Clinical Features
- 3. Diagnosis
- 4. Treatment
- 5. Zoonotic Aspects and Prevention
- ์ฐ๋ฆฌ๋๋ผ๋ ์ฃผ๋ก B gibsoni
- 2022๋ B. canis ์ ๊ตญ๋ด ์ต์ด ๋ณด๊ณ ๊ฐ ์์๋ค.
1. Etiology & Epidemiology
- RBC์ ๊ธฐ์ํ๋ ์์๋๋ฌผ์ด๋ค.
- Anemia ๊ด๋ จ ์ฆ์ ์ผ์ผํจ๋ค. (ํ์ํ ๊ฐ์, secondary IMHA, ITP ๋ฑ)
- ์ ์ธ๊ณ์ ์ผ๋ก ๋ถํฌํ๋ฉฐ(worldwide distribution), species๊ฐ ๋ค์ํ๋ค.

- ๊ณ ์์ด๋ ๊ฑธ๋ฆฌ๊ธฐ๋ ํ์ง๋ง, ๋๋ฌผ๋ค. (Babesiosis in cats : less common)
- ์ง๋ฅ์ด์์๋ ํนํ ๋ณผ ์ผ์ด ์ ์๋ค.
- ์ฐ๋ฆฌ๋๋ผ ์์ฃผ์์ 50๋ง๋ฆฌ ์ ๋์ ๊ธธ๋ฅ์ด๋ฅผ ๋์์ผ๋ก ๊ฒ์ฌํด๋ณด๋ 15% ์ ๋ ๊ฑธ๋ฆฐ ๊ณ ์์ด๊ฐ ์๊ธด ํ๋ค..
- ์ํ์ ํตํด ์ ํ๋ ์ ์์ผ๋ฏ๋ก, ์ํ ์ donor์ ํ์ก ๊ฒ์ฌ๊ฐ ํ์ํ๋ค! (screening test)

- B. canis, B. vogeli, B. gibsoni (pathogenic strains) ์ ๊ฐ์ผ๋ ๊ฒฝ์ฐ,
- ๋ฉฐ์น ~๋ช ์ฃผ์ incubation period ์กด์ฌ
- Degree of parasitemia(ํ์ก ์ ๊ธฐ์์ถฉ์ด ์กด์ฌํ๋ ์ ๋)๋ organism์ ๋ฐ๋ผ ๋ค์
- ๊ธฐ์์ถฉ์ RBC ๋ด์์ ๋ณต์ ๋์ด intravascular or extravascular hemolytic anemia ๋ฅผ ์ ๋ฐํ๋ค. (โ IMHA์ ๊ฐ๋ณ ํ์)
- ๊ธฐ์์ถฉ์ ๋ํ ๋ฉด์ญ ๋ฐ์(immune-mediated reactions)์ด๋, ํญ์ ๋ฐ์(altered self-antigens)์ด ์ฉํ์ฑ ๋นํ์ ์ ํ โ Coombs test ์์ฑ์ ์ ๋ฐํ ์ ์๋ค.
- Macrophage๋ฅผ ์๊ทนํ๋ค โ fever, hepatosplenomegaly
- ์ ํ๊ตฌ๋ฅผ ๋น ๋ฅด๊ฒ ํ๊ดด์ํจ๋ค โ ์ฐ์๋ฅผ ์ ์ด๋ฐํ์ง ๋ชปํ๋ฏ๋ก severe hypoxia, 2์ฐจ์ ์ฅ๊ธฐ ์์์ ์ ๋ฐํ ์ ์๋ค.
- ๊ธ์ฑ ๊ฐ์ผ๋ ์ผ๋ถ ๊ฐ์์๋ DIC๋ก ์ธํด ํ์ํ ๊ฐ์
- ์ฌ๊ฐ๋๋ ๋ค์ 2๊ฐ์ง์ ์ํฅ์ ๋ฐ๋๋ค: 1) Babesia ์ species&strain, 2) hostโs immune status
- Chronic, subclinical๋ ํํ๋ค. (์ฆ์์ด ์์ด ์ง๋จ์ด ์ ๋๊ธฐ๋ / ์ ๊ทน์ ์น๋ฃ ์ ํด๋ ๋จ)
- Glucocorticoids, splenectomy ๋ ๋น์ฅ ์ข ์ ๋ฑ ๋ค๋ฅธ ๋ฌธ์ ๊ฐ ๋๋ฐ๋์์ ๋ ์ง์๋๋ค. (๋จ์ผ ๊ฐ์ผ ์ ๊ถ์ฅ๋์ง ์์)
- Bartonella spp. ์ coinfection โ ๋ ์ฌ๊ฐ (๊ตญ๋ด์๋ ์ ์์)
2. Clinical Features
๋ฏธ๊ตญ์์ ์ค์์ํ(subclinical infection)์ด ํํจ.
| Clinical forms | |
|---|---|
| Peracute Acute | Anemia & fever ์ ์ ๋ฐํ๋ค. ๋นํ โ pale MMC / tachycardia, tachypnea / depression, anorexia, weakness (๋นํน์ด์ ) ์ฉํ์ฑ ๋นํ โ ํฉ๋ฌ, petechiae, hepatosplenomegaly (์ฌํ ๊ฒฝ์ฐ ์ด์ง์ผ๋ก๋ ๋๊ปด์ง ์ ์์) : ๊ฐ์ผ์ ๋จ๊ณ, DIC์ ๋๋ฐ ์ ๋์ ๋ฐ๋ผ ๋ค๋ฆ |
| acute | severe anemia, DIC, metabolic acidosis, renal disease South Africa์์์ B. rossi ๊ฐ์ผ์ด ๊ฐ์ฅ ์ฌ๊ฐํ๋ค. ์ฌ๊ฐํ ๊ฒฝ์ฐ tissue hypoxemia๋ ๋ํ๋๋ค : ์ฐ์ ๊ณต๊ธ์ด ์ค์ |
| Acute babesiosis๋ ๋ค์๊ณผ ๊ฐ๋ณ์ง๋จ ํ์ : Primary IMHA & Primary ITP (PCR ๊ฒ์ฌ) | |
| Chronic | Weight loss, anorexia |
| Atypical | ํ์ก์๋ ์๋๋ฐ ๋ณต์/์ฌ๋ญ์์์ DNA๊ฐ ๊ฒ์ถ๋๊ธฐ๋ ํจ. ์ ํ์ ์ธ Babesiosis ์ฆ์์ด ์๋๋ผ๋ ์ฒด์ก์์ ๊ฒ์ถ๋๋ ๊ฒฝ์ฐ๊ฐ ์์. |
3. Diagnosis
๋นํ์ด ์๋ค > Blood smear > CBC์์ ์ด์์ด ์ค์ ๋ก ๋นํ์ธ์ง / ๋ด์ ์ฒด๊ฐ ๋ฐ๊ฒฌ๋๋์ง ํ์ธ!
- Spherocytic regenerative anemia, thrombocytopenia
- (๋นํน์ด์ ) hyperbilirubinemia, bilirubinuria, hemoglobinuria, metabolic acidosis, azotemia, polyclonal gammopathy, proteinuria, cylindruria
- RBC์ organism ํ์ธ! (but ์ผ์์ ๊ด์ฐฐ๋์ง ์์ ์ ์์.)
- ๋ชจ์ธํ๊ด์์ ํ์ก์ด ์กฐ๊ธ ๋ ์ ์ฒด๋ผ์ ์ ๋ณด์ผ ์ ์์.
| B. gibsoni | B. canis | B. coco |
|---|---|---|
| canis ๋ณด๋ค ๋ ์์. ์์ ์ ๋ชจ์ | ์กฐ๋กฑ๋ฐ ๋ชจ์ ๋ง์ด์์๋ ring ๋ชจ์ | ์ข ๋ ์์ ๋ถ๋ฐฉํ ํํ |
![]() | ![]() | ![]() |
- ์์์ ์ผ๋ก ์ ์์ด๋ ํญ์ฒด ๋ฐ์ ์์ฑ์ธ ๊ฒฝ์ฐ๊ฐ ๋ง์. > ํ์ฌ ๊ฐ์ผ์ด ์๋ ์๋ ์์ผ๋,
- ํญ์ฒด ๊ฒ์ฌ๋ง์ผ๋ก ํ์งํ๊ธฐ๋ ์ด๋ ค์.
PCR assays
- ๋ฏธ๊ตญ์์ ์ฃผ๋ก ์งํ. B. vogeli ์ B. gibsoni ๋ฅผ ์ฐพ์์ฃผ์ง๋ง, ์ข ๊ตฌ๋ถ์ ๋ถ๊ฐ.
- ์์์ฑ : peracute disease, concurrent immunosuppression, ์ง๋ณ ์ด๊ธฐ ํญ์ ์์ด ์ ๊ฑฐ๋, ๊ฒ์ฌ ๊ธฐ์ค์ ์ฐจ์ด๋ก ์ธํด
- ์์์ฑ(seropositive) : ์ง๋ณ์ ๊ฑธ๋ ธ๋ค๊ฐ ์น๋ฃ๋์ด ๋ชธ์ ํญ์์ด ๋จ์์๋ ๊ฒฝ์ฐ โ ํญ์ ์์ฒด๋ก๋ ํ์ ์ง๋จ ๋ถ๊ฐ.
[๊ตญ๋ด PCR assays ํ๊ฒฝ]
-
Babesia ๋ฅผ ๊ฐ๋ณํ๋ ๋ฐ ๊ฐ์ฅ ์ข์ - RBC์ ๊ธฐ์, ์ ํ ์ํ ํ์.
- ํ๊ฒ ์ํด ๋ฝ์ ๋ PCR์ฉ๋ ๊ผญ ๋จ๊ฒจ๋์ (์ ํ 1ml)
-
์ฅ์ ) ๊ฐ๋จํ๊ณ , ์ฌ๋ ์์ ๋ ํ๋ ํธ.
-
์ฃผ์์ ) ์คํ ๋ก์ด๋ ์น๋ฃ ์์ ์ โ ๊ฒ์ฌ ๊ฒฐ๊ณผ๊ฐ ๊ฐ๋ ค์ง ์ ์์.
-
Subclinical carriers๊ฐ ์๋ ๊ฒฝ์ฐ, ์์ฑ ๊ฒฐ๊ณผ๊ฐ ๊ผญ ์์ ์ฆ์์ ๋ํ๋ด์ง๋ ์์.
-
ํ์ง๋ง ์ฆ์์ด ์์ ๋์ ๊ฒ์ฌ๋ ์์์ ์์๊ฐ ์์.
[๊ณ ์์ด]
- Acute phase proteins : serum amyloid A (๊ณ ์์ด โ), haptoglobin, paraoxonase-1
- ๊ต์ฅํ ์์์ ๋๋ฌผ์์, subclinical Babesia carrier์ ์์ ์ฆ์์ด ๋ํ๋ ๋๋ฌผ์์ ์ ์๋ฏธํ ์ฐจ์ด๊ฐ ์์.
- serum haptoglobin ์ฆ๊ฐ & paraoxonase-1 ๊ฐ์
4. Treatment
2๊ฐ์ง๋ก ์ ๊ทผ.
- Supportive care : ์ํ, ์คํ์ฐ์ผ ์น๋ฃ, ์์ก ์น๋ฃ
- Drugs : atovaquone (๋ค๋ฅธ ์ฝ๋ฌผ์ ์ค์x)
Drugs
| In US |
|---|
| (1) B. vogeli ๊ฐ ์์ฌ๋ ๋ : Imidocarb diproprionate |
| - 5-6.6mg/kg twice, 14days apart ๋๋ 7.5mg/kg once SC or IM - gibsoni์ ๋ํด์๋ ๋จ๋ ์ ์ ๋ก ํจ๊ณผ์ ์ด์ง ์์. |
| (2) B. gibsoni ๊ฐ ์์ฌ๋ ๋ : azithromycin + atovaquone |
| [ Azithromycin (10 mg/kg PO q24h) + atovaquone (13.3 mg/kg PO q8h)๏ผฝfor at least 10 days - ๊ธฐ๋ฆ์ง ์์, ์์ด์คํฌ๋ฆผ๊ณผ ๊ฐ์ด ๋จน๋๋ค : ๊ตฌํ ๋ฅผ ๋ง์ด ํ๊ธฐ ๋๋ฌธ |
- ๊ตญ๋ด protocols : Azithromycin + atovaquone์ด first choice์ง๋ง, ์ ๋๊ธฐ๋ ํด์ ๋ค์ํ ์ฝ๋ฌผ ์กฐํฉ์ด ์ ์๋จ..
| In Asia |
|---|
| (1) AA protocol : Azithromycin (10 mg/kg PO q24h) + atovaquone (13.3 mg/kg PO q8h) for 10 days |
| : ๊ตญ๋ด์์ 1์์๋ก ์ ํ๋๋ ๋ฐฉ๋ฒ |
| (2) Clindamycin (30 mg/kg PO q12h) + diminazene (3.5 mg/kg IM, a single dose on the day of presentation) + imidocarb (6 mg/kg SC, a single dose on the day after the diminazene was administered) |
| (3) Doxycycline (7-10 mg/kg q12h) + enrofloxacin (2-2.5 mg/kg q12h) + metronidazole (5-15 mg/kg q12h) |
| : 2๊ฐ์ง๊ฐ ๊ต์ฌ์์ second, third choice๋ก ์ ์๋์์ง๋ง.. |
| * MCD protocol : Metronidazole + Clindamycin + Doxycycline (for 30/60/90 days) |
| : ์ค์ง์ ์ธ 2์์๋ MCD protocole. : AA์์ failํ ๋๋ฌผ๋ค์ 80%์์ MCD protocol์ด ์น๋ฃ ํจ๊ณผ๋ฅผ ๋ด. |
โ 100% ๋ซ๊ฒ ํ๋ ์กฐํฉ์ ์์ง ์์.
5. Zoonotic Aspects and Prevention
- ๊ฐ, ๊ณ ์์ด โ ์ฌ๋์ผ๋ก ์ ํ๋ ์ผ์ด์ค๋ ์์ง๋ง, ์ฃผ์๋ ํ์ํจ!
- B. microti ๋ ์ฌ๋์๊ฒ ๊ฐ์ผ ๊ฐ๋ฅ
- Minimal cross-protection : ํ ๋ฒ ๊ฑธ๋ ธ์ด๋ ๋ค๋ฅธ species์ ๊ฑธ๋ฆด ๊ฐ๋ฅ์ฑ ์์
- ๋ฉด์ญ์ต์ ์ , ๋น์ฅ์ ์ ์ : ๊ณผ๊ฑฐ ๊ฐ์ผ๋์๋ ๊ฐ์์๋ ์ํ
- ๊ฐ๋ฌผ๋ฆผ์ฌ๊ณ : ์กฐ์ฌํด๋ผ
- ๋ฐฑ์ ? : ์๋ ๋๋ผ๋ ์์ง๋ง, ๋ฏธ๊ตญ๊ณผ ์ฐ๋ฆฌ๋๋ผ์๋ ์์
- Blood donor programs : ๊ผญ PCR screening์ ๊ฑฐ์น๊ณ ๋์ ๊ณตํ
[๊ตฌ์ถฉ์ ]
- Revolution + Advocate = Nexgard spectra